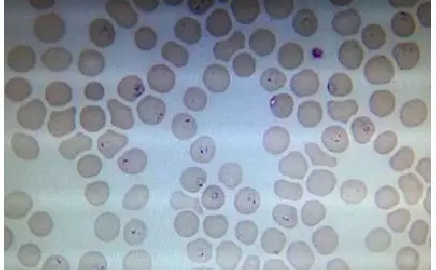

2016年11月03日
转氨酶为什么会升高?单项酶升高能说明什么?
阅读全文2016年11月03日
总胆红素偏高和偏低的原因
阅读全文
2016年11月02日
案例分析┃好高的网织红,原来是你在作怪?
阅读全文
2016年11月02日
丙氨酸氨基转移酶(ALT)的介绍及临床意义
阅读全文2016年11月01日
肺癌相关实验室检测有哪些?
阅读全文2016年11月01日
24小时尿蛋白定量接近正常值高限,是肾有问题了吗?
阅读全文2016年10月28日
细数血清酶检查的干扰因素
阅读全文2016年10月28日
高尿酸血症与肾功能恶化
阅读全文2016年10月27日
不孕不育检测项目大全
阅读全文艾迪康医学检验中心 © 版权所有 法律声明 浙ICP备07020270号-1 浙公网安备33010602009212号